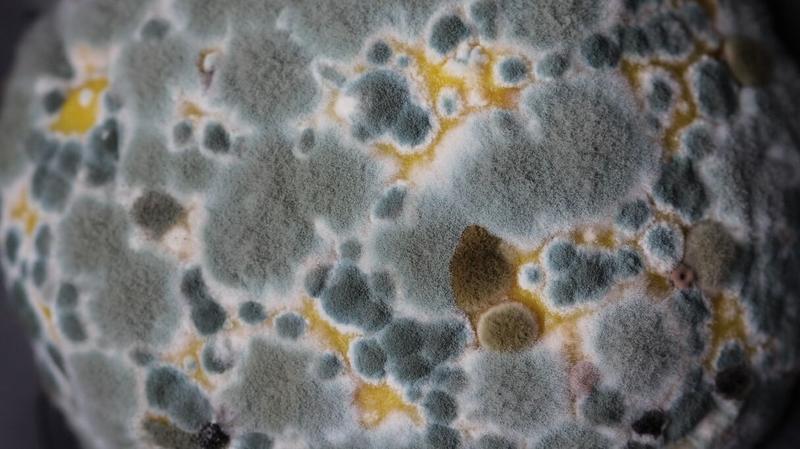
Ryzyko spożycia pleśni

Pleśń, choć mało urocza, to grzyb, który nie tylko zjada nasze jedzenie, ale bywa także groźny dla naszego zdrowia. Zazwyczaj pojawia się w idealnych warunkach, czyli w wilgotnym i ciepłym środowisku. Na szczycie listy produktów, które powinny budzić nasz niepokój, znajdują się chleb, owoce i warzywa. Właściwie możemy stworzyć ranking, ponieważ pleśń uwielbia rozwijać się w miejscach, gdzie nie jest mile widziana. Co gorsza, jej obecność może stwarzać niebezpieczeństwo – gdy dojrzeje, wydziela mikotoksyny, które stanowią dla nas realne zagrożenie. Dlatego, jeśli natrafisz na spleśniałego pomidora w sałatce, zdecydowanie lepiej się go pozbyć niż ryzykować!
Od czasu do czasu każdy smakosz musi zmierzyć się z tą lepką kwestią – zjedzenie pleśni zazwyczaj kończy się jedynie nieprzyjemnymi dolegliwościami, takimi jak ból brzucha, nudności czy zawroty głowy. Niemniej jednak, nie ma sensu się zapierać – pleśń naprawdę nie jest miłą niespodzianką, ale nasz organizm dysponuje skutecznymi mechanizmami obronnymi, które, przy odrobinie szczęścia, szybko poradzą sobie z intruzem. W przypadku sporadycznego zjedzenia małego kawałka spleśniałego ananasa, nie ma co panikować, chyba że zaczniemy fascynować się tą mroczną stroną kulinariów!
Warto jednak pamiętać, aby nie przekraczać pewnych granic – regularne spożywanie pleśni przypomina uprawianie ekstremalnego sportu, co zdecydowanie nie jest polecane przez lekarzy. Mikotoksyny, które są złośliwymi cząsteczkami, mogą powodować poważne problemy zdrowotne. Działają niczym taran, który niespodziewanie burzy nasze zdrowie, mogąc prowadzić do raka lub uszkodzenia narządów wewnętrznych. Dlatego właśnie lepiej trzymać się pewnych zasad, na przykład jeść świeże owoce i warzywa. Nie zapominaj także, aby nie karmić zwierząt spleśniałym jedzeniem – one mogą mieć jeszcze mniej szczęścia niż my!
Pleśń zawsze budzi emocje, zarówno w kuchni, jak i przy wyborze serów pleśniowych, które wszyscy znamy i lubimy. I tak, dobrze słyszeliście – nie wszystkie pleśnie są wrogie. Wiele z nich starannie hodujemy w celach kulinarnych. Sery takie jak camembert czy roquefort opierają się na specjalnych rodzajach pleśni, które są w pełni bezpieczne do spożycia. Dlatego gdy przyjdzie ci do głowy, aby wymienić pleśniowe brie na świeżutki kawałek z supermarketu, warto przemyśleć tę decyzję dwa razy. Bowiem pleśniowe czary mogą być zarówno przyjaciółmi, jak i wrogami w naszym dążeniu do zdrowego stylu życia.

Poniżej znajdują się niektóre z popularnych serów pleśniowych, które mogą być spożywane bez obaw:
- Camembert
- Roquefort
- Gorgonzola
- Brie
| Temat | Fakty | Mity |
|---|---|---|
| Pleśń a zdrowie | Pleśń może wydzielać mikotoksyny, które są groźne dla zdrowia. | Nie ma dużego ryzyka przy sporadycznym zjedzeniu małej ilości pleśni. |
| Objawy po spożyciu pleśni | Mogą wystąpić bóle brzucha, nudności i zawroty głowy. | Objawy są zawsze poważne i wymagają natychmiastowej interwencji. |
| Regularne spożywanie pleśni | Może prowadzić do poważnych problemów zdrowotnych, w tym do raka. | Nie ma konsekwencji zdrowotnych związanych z regularnym spożywaniem pleśni. |
| Pleśń a sera pleśniowe | Pleśń jest zawsze niezdrowa i należy jej unikać za wszelką cenę. | |
| Przykłady bezpiecznych serów pleśniowych | Camembert, Roquefort, Gorgonzola, Brie są bezpieczne do spożycia. | Wszystkie sery pleśniowe należy unikać, niezależnie od ich rodzaju. |
Czy wiesz, że niektóre pleśnie, takie jak Penicillium, są wykorzystywane w medycynie do produkcji antybiotyków, co pokazuje, że pleśń może mieć zarówno korzystne, jak i szkodliwe właściwości?
Reakcje organizmu na spożycie spleśniałych produktów
Pleśń, niewidzialny wróg w naszej kuchni, potrafi zaatakować w najmniej oczekiwanym momencie. Wędrowa po pieczywie, owocach czy serze, przypomina nieproszonych gości, którzy zjawiają się, gdy najmniej ich oczekujemy. Co się dzieje, kiedy natrafimy na spleśniałe jedzenie? Zazwyczaj nie przynosi to nic dobrego, choć spokojnie – małe ilości pleśni zazwyczaj nie wyrządzają nam poważniejszej krzywdy. Może co najwyżej spożycie spleśniałego jogurtu wywoła nieco rozdrażnienia w żołądku, a z pewnością towarzyszyć temu będzie nieprzyjemny smak przypominający mokry brud, który przetrwał w kuchennej szafie. Z całą pewnością będzie to nauczka na przyszłość, by ze skrupulatnością sprawdzać, co kryje się w środku.

Jednak pojawia się ważna uwaga – sprawa komplikuje się wtedy, gdy pleśń ma czas na rozwój i zaczyna produkować mykotoksyny, te wszechobecne zagrożenia, które potrafią zafundować nam niezłą rewolucję żołądkową. Oczywiście, nie każda pleśń musi być groźna. Niektóre, na przykład te wytwarzane w produktach takich jak sery pleśniowe, zostały sklasyfikowane jako „dopuszczalne” i można je spożywać bez wyrzutów sumienia. Niemniej jednak, gdy dostrzegamy zielony nalot na chlebku, lepiej zaryzykować i rozważyć wyrzucenie go, niż narażać się na „pleśniowe odchudzanie” w postaci biegunki czy wymiotów.
Interesujący jest fakt, że każdy z nas może przypadkowo spożyć pleśń. Niezależnie od tego, czy wystąpi to w pieczywie pozostawionym w nieodpowiednich warunkach, czy w ulubionym owocu, który zbyt długo leżał w lodówce, jeśli do tego dojdzie, nie wpadaj w panikę. Zazwyczaj, jeśli ilość spożytej pleśni była niewielka, organizm ma szansę poradzić sobie sam, uruchamiając obronne mechanizmy niczym przy alarmie. Warto rozważyć lekką dietę bogatą w błonnik, by „usunąć nieproszonych gości” z naszego układu pokarmowego w sposób naturalny. Jak mawiali starożytni, „lecz się w stylu ezen z pleśnią, szybciej orzechy odpłyną”. Tak, dobrze to mówię: orzechy, bo pleśnie lubią czaić się także w nich.
Na koniec chcę przypomnieć, aby pamiętać, że prewencja jest kluczowa! Właściwe przechowywanie żywności oraz regularne przeglądanie zapasów stanowią podstawowe sposoby na uniknięcie „pleśniowych niespodzianek”. Poniżej znajduje się kilka wskazówek, jak zapobiegać pleśni w naszej kuchni:
- Przechowuj żywność w szczelnych opakowaniach.
- Regularnie przeglądaj daty ważności produktów.
- Unikaj trzymania owoców i warzyw w zamkniętej przestrzeni.
- Utrzymuj czystość w kuchennych szafkach i lodówce.
- Nie kupuj jedzenia w nadmiarze, aby uniknąć psucia się.
Kupujmy w rozsądnych ilościach i śmiało wyrzucajmy podejrzane produkty. W końcu, jeśli to, co trafia do naszego żołądka, wróci z nieprzyjemnym efektem, lepiej po prostu to wyrzucić! Przy odpowiedniej dbałości o jedzenie pleśń trzyma się z daleka od naszej kuchni, a my będziemy czerpać radość z świeżych i przede wszystkim zdrowych posiłków.
Czy pleśń jest zawsze niebezpieczna? Oceniając ryzyko
Pleśń to zjawisko, które towarzyszy nam przez całe życie, podobnie jak nielubiany sąsiad, uporczywie zapraszający się na kawę. Wiele osób natknęło się na nią, otwierając lodówkę, gdzie zauważyliśmy zielony, szary lub czarny meszek. Jednakże wiele osób ignoruje fakt, że pleśń sama w sobie nie zawsze jest niebezpieczna. Można powiedzieć, że to grzyb w lekkim wydaniu, który rozkwita w odpowiednich warunkach, zazwyczaj na wilgotnym i ciepłym podłożu. Mimo iż warto posiadać pewne techniczne umiejętności w radzeniu sobie z pleśnią, pamiętajmy, że najczęściej nie stanowi ona groźby. O wiele większe zagrożenie stwarzają mykotoksyny wydzielane przez niektóre gatunki, zwłaszcza gdy już się rozwiną.

Pewnie wielu z nas ominęło zakazany owoc w postaci spleśniałego chleba i z entuzjazmem wgryzło się w kromkę. Choć raz na jakiś czas kawałek pleśni może nam nie zaszkodzić, regularne takie eksperymenty mogą przynieść spore kłopoty. Szybko mogą wystąpić objawy ze strony układu pokarmowego, takie jak ból brzucha czy nudności, a w poważniejszych przypadkach możemy doświadczać wymiotów i biegunki. Zanim jednak wpadniecie w panikę, warto zauważyć, że większość ludzi, a zwłaszcza ci stosujący naturalne metody obrony organizmu, poradzi sobie z małym skandalem pokarmowym bez większego uszczerbku na zdrowiu.
Ale chwila! Jak rozpoznać szkodliwe pleśnie? To proste! Gdy widzicie kolorową pleśń kusiącą swoją „zielenią” lub czarne grudki, od razu powinny zapalić się lampki ostrzegawcze. Takie produkty należy natychmiast usunąć, ponieważ pleśń skutecznie wnika w głąb jedzenia. Możecie myśleć, że reszta produktu jest w idealnym stanie, ale niestety – mykotoksyny mogą ukrywać się głęboko. Warto mieć na uwadze, że pleśń atakuje nasz talerz na tych samych zasadach, co pasożyt osiedlający się w ocieplonym gniazdku.

Na końcu warto podzielić się kilkoma praktycznymi radami. Oto, co możecie zrobić, aby uniknąć pleśni:
- Ograniczajcie wilgoć w kuchni.
- Regularnie sprzątajcie lodówkę.
- Przechowujcie żywność w odpowiednich warunkach.
- Unikajcie zapasywania jedzenia, które nie ma daty „ważności” na wieki.
Tego nie da się całkowicie uniknąć, ale postarajcie się dbać o to, co trafia na Wasz talerz i nie dajcie się skusić pleśniowym czarom. Pamiętajcie, pleśń działa jak przestroga – lepiej dmuchać na zimne, niż później żałować z plikiem papierków w toalecie.
Profilaktyka: Jak unikać pleśni w codziennej diecie
Pleśń w jedzeniu to nic przyjemnego. Można by powiedzieć, że pleśń to taki nieproszony gość, który wkracza, robi bałagan i niszczy nasze zapasy. Choć pleśń pełni naturalną rolę w recyklingu żywności, zdecydowanie nie chcemy, aby to właśnie nam przyszło płacić za jej obecność. Żeby skutecznie unikać pleśni w codziennej diecie, najpierw musimy zwrócić uwagę na sposób przechowywania produktów. Kluczowym elementem jest wysoka temperatura oraz wilgoć, ponieważ pleśń uwielbia to połączenie. W związku z tym, lodówka powinna stać się naszym najlepszym przyjacielem! Koniecznie utrzymuj ją w czystości i zawsze pamiętaj, by nie wkładać do niej zepsutych produktów, gdyż pleśń potrafi rozprzestrzeniać się jak zaraźliwy wirus.
Nie daj się zwieść, że zjedzenie kawałka spleśniałego chleba zakończy się jedynie złym samopoczuciem oraz smutkiem w sercu. Jednak nie ma potrzeby panikować, ponieważ w przypadku takiego niemiłego incydentu, organizm zazwyczaj potrafi zareagować. Wymioty i biegunka stanowią jego naturalny sposób obrony. Oczywiście należy za wszelką cenę unikać spożywania pleśni! Jeżeli pleśń próbuje zaprosić nas na kolację, to najlepiej, aby była to pleśń z serów – jest ona pożądana, w przeciwieństwie do pleśni w mleku czy owocach, która jedynie prowadzi do bólu brzucha i zmartwień!
Aby skutecznie zabezpieczyć się przed pleśnią, warto również poświęcić chwilę na przemyślane zakupy. Dokonuj zakupu mniejszych ilości żywności – zdecydowanie lepiej jest regularnie uzupełniać zapasy niż niepotrzebnie ładować do lodówki całe hurtownie. Staraj się trzymać produkty o krótkiej dacie ważności w szczelnych pojemnikach, a pieczywo chować do zamrażarki. Ponadto, korzystaj z przypraw, które posiadają długi termin trwałości i są dobrze zapakowane. Dzięki temu zminimalizujesz ryzyko nieprzyjemnych niespodzianek, ponieważ pleśń potrafi czaić się tam, gdzie najmniej się jej spodziewasz!
- Dokonuj zakupu mniejszych ilości żywności.
- Trzymaj produkty o krótkiej dacie ważności w szczelnych pojemnikach.
- Chowaj pieczywo do zamrażarki.
- Korzystaj z przypraw, które mają długi termin trwałości.
Poniżej przedstawione są kluczowe zasady dotyczące zakupów, które pomogą uniknąć pleśni w diecie.
Gdy już zadbamy o to, aby pleśń nie zagościła w naszej diecie, nie zapomnijmy o higienie – regularne czyszczenie lodówki to klucz do sukcesu! Czysta lodówka to nie tylko brak pleśni, ale także gwarancja naszego zdrowia na talerzu. Pamiętajmy: pleśni w diecie zdecydowanie nie chcemy, natomiast czystości i świeżości – jak najbardziej. Więc do roboty! Szybka akcja jest konieczna, ponieważ pleśń może być gotowa zaatakować z każdej strony!
